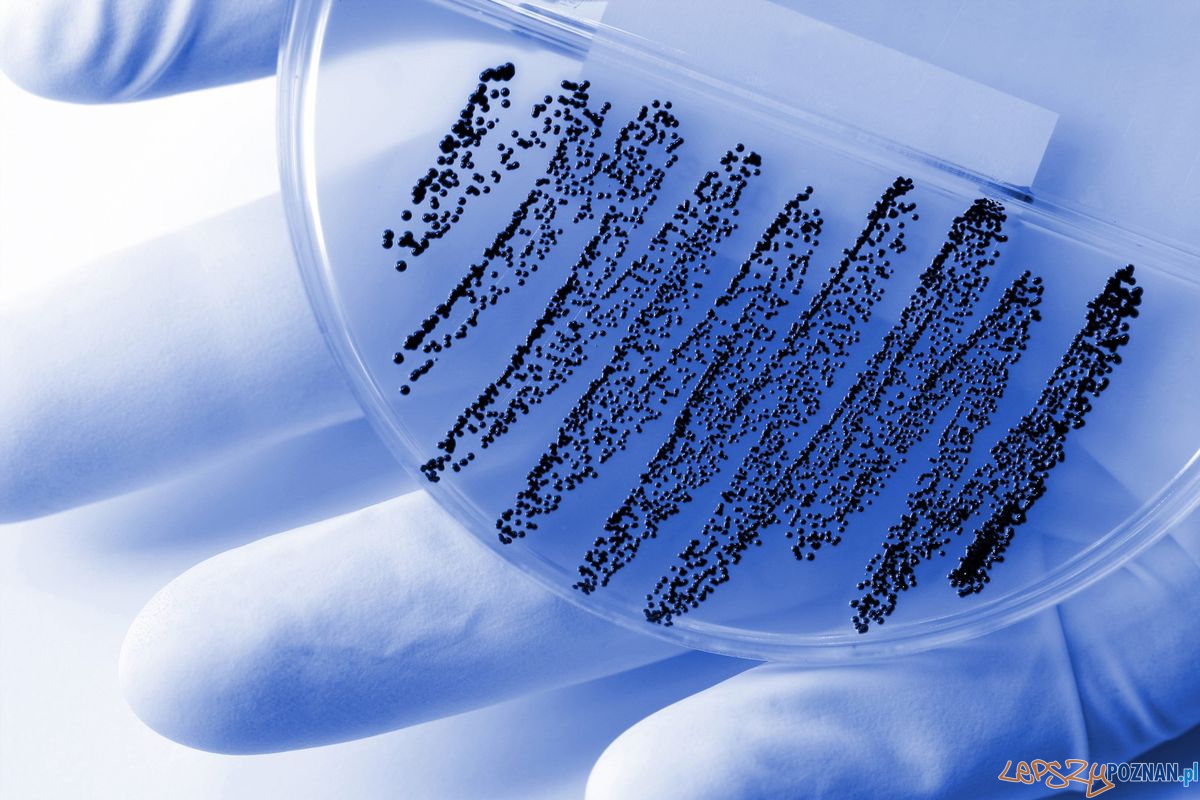

Polacy nie przestrzegają podstawowych zasad higieny podczas przygotowywania posiłków. Mimo to 83 proc. jest przekonana, że szybciej zatruje się w restauracji niż we własnej kuchni. Właśnie wystartowała kampania edukacyjna „Higieniczna Kuchnia”, która ma uświadomić, że drobnoustroje, które „zjadamy” na co dzień, są najczęstszą przyczyną zatruć.
Polacy nie dbają o higienę w kuchni – 64 proc. respondentów badania TNS Global przeprowadzonego na zlecenie Fundacji BOŚ nie myje lodówki przynajmniej raz w miesiącu. Ponad połowa ankietowanych przyznaje również, że odkrawa kawałek nadpsutego owocu lub warzywa, a resztę – zawierającą m.in. komórki pleśni – zjada. Tymczasem pleśnie wytwarzają mikrotoksyny (np. patulinę), które uszkadzają wątrobę i nerki oraz mogą być przyczyną powstawania nowotworów. Podstawowych zasad higieny brakuje też w przechowywaniu żywności oraz przygotowywaniu posiłków.
Z badania wynika, że aż 55 proc. osób nie myje jaj przed obróbką cieplną, nie zdając sobie sprawy, że na skorupce mogą znajdować się m.in. bakterie Salmonelli.
Musimy pamiętać, że bakterie, które znajdują się na skorupce jaj zostają na naszych dłoniach, którymi później nakładamy pomidora na kanapkę lub kroimy pieczywo – podkreśla Maria Jakubowska, Ekspert ds. Żywienia w Fundacji BOŚ. – Mycie skorupki jest kluczowe, zwłaszcza jeśli przygotowujemy kogel-mogel lub ciasto z kremem jajecznym, a więc produkty, które nie wymagają parzenia, gotowania oraz pieczenia. Wtedy zagrożenie jest naprawdę realne – dodaje Jakubowska. O jakich zagrożeniach mowa? Przede wszystkim o bakteriach Salmonelli, które wywołują ostre wymioty, biegunkę i gorączkę, a także o jajach pasożytów, które zostają na skorupce wraz z kurzymi odchodami.
Blisko połowa Polaków przyznaje (48 proc.), że kroi surowe mięso na tej samej desce co warzywa i inne produkty spożywane bez obróbki cieplnej. Tymczasem bakterie z surowego mięsa zostają nie tylko na desce, ale również na naszych dłoniach. Już 500 komórek bakterii Campylobacter jejuni, rozwijającej się w surowym mięsie drobiowym wystarczy, by wywołać ostrą biegunkę i gorączkę 40 st. C. Powikłaniem takiego zatrucia może być zapalenie opon mózgowych lub posocznica, a 500 komórek bakterii to bardzo mało – dla przykładu, w kubeczku jogurtu jest ich aż 150 milionów (i są to – na szczęście – dobre bakterie). Jak niwelować niebezpieczeństwo? – Po pierwsze powinniśmy myć ręce nie tylko przed przygotowywaniem posiłku, ale również w jego trakcie np. po krojeniu surowego mięsa.
W każdym domu powinny być różne deski do krojenia mięsa oraz innych produktów. Łatwym sposobem jest kupienie desek w różnych kolorach np. czerwonej do mięsa, niebieskiej do ryb, zielonej do warzyw – podpowiada Aleksandra Koper, Ekspert ds. żywienia w Fundacji BOŚ.
Zresztą od mycia rąk wszystko się zaczyna. Na dłoniach przenosimy bowiem jaja tasiemca i innych pasożytów, pałeczki Salmonelli, patogenne Escherichia coli, gronkowiec złocisty, czy rotawirusy. Według Światowej Organizacji Zdrowia aż 69 proc. zakażeń przewodu pokarmowego wynika z niemycia rąk i zarazków przenoszonych właśnie tą drogą. Zazwyczaj myjemy ręce zbyt szybko i niedokładnie. Tymczasem, by pozbyć się bakterii, powinniśmy szorować je mydłem lub detergentem przynajmniej przez 14 sekund.

Dodaj komentarz